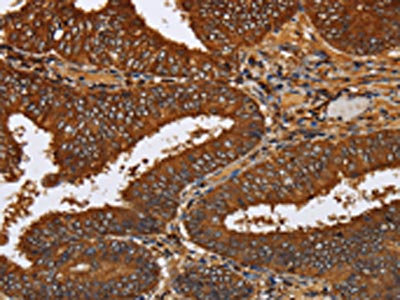

TICAM2 Antibody
-
中文名稱(chēng):TICAM2兔多克隆抗體
-
貨號(hào):CSB-PA043920
-
規(guī)格:¥1100
-
圖片:
-
The image on the left is immunohistochemistry of paraffin-embedded Human colon cancer tissue using CSB-PA043920(TICAM2 Antibody) at dilution 1/60, on the right is treated with fusion protein. (Original magnification: ×200)
-
The image on the left is immunohistochemistry of paraffin-embedded Human brain tissue using CSB-PA043920(TICAM2 Antibody) at dilution 1/60, on the right is treated with fusion protein. (Original magnification: ×200)
-
-
其他:
產(chǎn)品詳情
-
Uniprot No.:
-
基因名:TICAM2
-
別名:Putative NF-kappa-B-activating protein 502 antibody; TCAM2_HUMAN antibody; TICAM-2 antibody; TICAM2 antibody; TIR containing adapter molecule 2 antibody; TIR domain containing adaptor protein antibody; TIR domain-containing adapter molecule 2 antibody; TIRAP 3 antibody; TIRAP3 antibody; TIRAP3a short form antibody; TIRP antibody; Toll-like receptor adaptor protein 3 antibody; Toll/interleukin-1 receptor domain-containing protein antibody; TRAM antibody; TRIF-related adapter molecule antibody
-
宿主:Rabbit
-
反應(yīng)種屬:Human
-
免疫原:Fusion protein of Human TICAM2
-
免疫原種屬:Homo sapiens (Human)
-
標(biāo)記方式:Non-conjugated
-
抗體亞型:IgG
-
純化方式:Antigen affinity purification
-
濃度:It differs from different batches. Please contact us to confirm it.
-
保存緩沖液:-20°C, pH7.4 PBS, 0.05% NaN3, 40% Glycerol
-
產(chǎn)品提供形式:Liquid
-
應(yīng)用范圍:ELISA,IHC
-
推薦稀釋比:
Application Recommended Dilution ELISA 1:2000-1:10000 IHC 1:100-1:300 -
Protocols:
-
儲(chǔ)存條件:Upon receipt, store at -20°C or -80°C. Avoid repeated freeze.
-
貨期:Basically, we can dispatch the products out in 1-3 working days after receiving your orders. Delivery time maybe differs from different purchasing way or location, please kindly consult your local distributors for specific delivery time.
-
用途:For Research Use Only. Not for use in diagnostic or therapeutic procedures.
相關(guān)產(chǎn)品
靶點(diǎn)詳情
-
功能:Functions as sorting adapter in different signaling pathways to facilitate downstream signaling leading to type I interferon induction. In TLR4 signaling, physically bridges TLR4 and TICAM1 and functionally transmits signal to TICAM1 in early endosomes after endocytosis of TLR4. In TLR2 signaling, physically bridges TLR2 and MYD88 and is required for the TLR2-dependent movement of MYD88 to endosomes following ligand engagement. Involved in IL-18 signaling and is proposed to function as a sorting adapter for MYD88 in IL-18 signaling during adaptive immune response. Forms a complex with RAB11FIP2 that is recruited to the phagosomes to promote the activation of the actin-regulatory GTPases RAC1 and CDC42 and subsequent phagocytosis of Gram-negative bacteria.; Proposed to inhibit LPS-TLR4 signaling at the late endosome by interaction with isoform 1 thereby disrupting the association of isoform 1 with TICAM1. May be involved in TLR4 degradation in late endosomes.
-
亞細(xì)胞定位:[Isoform 1]: Cytoplasm. Golgi apparatus. Cell membrane. Endoplasmic reticulum. Early endosome membrane. Late endosome membrane. Cell projection, phagocytic cup. Note=Localized to the plasma membrane as a result of myristoylation. Phosphorylation on Ser-16 leads to its depletion from the membrane. Upon LPS stimulation colcoalizes with isoform 2 in late endosomes.; [Isoform 2]: Endoplasmic reticulum. Early endosome membrane. Late endosome membrane. Note=Translocates to late endosomes upon LPS stimulation where it colcoalizes with isoform 1.
-
組織特異性:Expressed in spleen, prostate, testis, uterus, small intestine, colon, peripheral blood leukocytes, heart, placenta, lung, liver, skeletal muscle, and pancreas Isoform 2 is ubiquitously expressed (at lower levels than isoform 1).
-
數(shù)據(jù)庫(kù)鏈接:
Most popular with customers
-
-
YWHAB Recombinant Monoclonal Antibody
Applications: ELISA, WB, IHC, IF, FC
Species Reactivity: Human, Mouse, Rat
-
Phospho-YAP1 (S127) Recombinant Monoclonal Antibody
Applications: ELISA, WB, IHC
Species Reactivity: Human
-
-
-
-
-